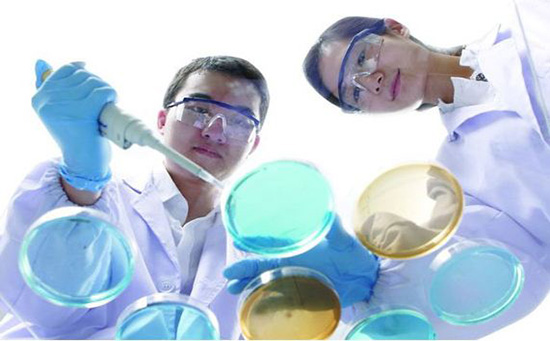

药业营销 Pharmaceutical Marketing
综合性药理学、法律学、企业管理学、社会经济学、社会心理学几科课程的专业知识,药物运营/管理方法是一门学科,它规定学员在药店的管理方法、药物的品质、方子的解决、药物的市场销售及其监管等层面的运用工作能力。药物现行政策及其药物管理方法全是比较偏重管理工作的,归属于应用性课程,而且这一方位的科学研究机遇少,得到学业奖学金的机遇也就少了。现阶段有零星的学员申请办理到药物社会经济学取得了offer和学业奖学金。

岗位市场前景:
医药业在美国式寥寥无几的金多制造行业。虽然美国看病难就医难的难题饱受诟病,医疗设备固然便捷但非常靠谱,因而药业营销也不容易出現中国药代陪吃陪喝的工作态度。美国在药业营销制造行业花销极大,依据早两年统计分析,美国一年再此制造行业内花销570亿美元。
岗位叙述:
药业营销必须另外了解药物科学研究及其营销方法。关键工作中有向医院、专家介绍药物,跟踪药物应用状况和实际效果,与医院及大夫保持联络。
预估薪酬:
药业营销归属于高薪职业,依据美国劳工局统计分析,药业营销均值薪资可超过13万美元上下
1.宾夕法尼亚大学
2 密歇根大学安娜堡分校
3 加州大学伯克利大学分校
4 德克萨斯大学奥斯汀
5 纽约大学
6 北卡罗来纳高校天主堂山分校
7 印第安纳大学伯明顿分校
8 弗吉尼亚大学
9 威斯康星大学麦迪逊分校